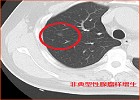
肺结节=肺癌?别再自己吓自己啦!

2022年4月15日至21日是第28个全国肿瘤防治宣传周,今年宣传周的主题是:“癌症防治早早行动”。旨在积极倡导每个人做自己健康的第一责任人,主动参加防癌健康体检,做到早预防、早发现、早诊断、早治疗,降低癌症发病率和死亡率,提高癌症早诊率和生存率,切实遏制癌症危害,提升群众健康水平。

肺癌、肝癌、胃癌、结直肠癌......由于大家生活方式的改变,我国癌症发病率持续增高。随着人们健康意识的提高,很多人在体检时做胸部CT检查,进而发现了越来越多的肺结节,为此寝食难安,怀疑自己得了肺癌,甚至严重焦虑而无法正常工作和生活。
什么是肺结节?
肺结节是胸片或CT发现肺内直径≤3cm的类圆形病灶,1cm以下的称为肺小结节,5mm以下的称为肺微小结节。
肺结节会是肺癌吗?
肺结节按性质分为良性结节和恶性结节。常见的良性结节有炎症、结核瘤、错构瘤、肺内淋巴结、血管瘤等。恶性结节有原发性肺癌和转移瘤等。还有一些是癌前病变,比如非典型性腺瘤样增生,这些癌前病变随着病变的进展,可发展为肺癌。据统计,结节越大恶性概率越大。

典型的错构瘤(内有爆米花样钙化)
为什么有肺结节的病人那么多?
以前人们体检都是做胸片,而胸片很难发现1cm以下的结节。而胸部CT连2mm左右的结节都可以发现,所以肺结节的检出率就高了。据统计,10-15%的健康人群初次体检时会发现肺结节,但绝大部分结节都是良性的。
磨玻璃结节是怎么回事?
胸部CT检查结论中常出现磨玻璃结节,肺部结节按密度高低分为纯磨玻璃结节、混合磨玻璃结节、实性结节。总体来看,纯磨玻璃结节、混合性磨玻璃结节、实性结节的恶性概率分别约为18%、63%、7%。

1、2为纯磨玻璃结节;3、4、5为混合性磨玻璃结节;6为实性结节
哪些肺结节恶性概率大?
简单来说,结节越大,恶性概率越大。从CT影像来看,混合性磨玻璃结节恶性概率高,如结节有分叶征、毛刺征、血管征等征象也要高度警惕。另外还要结合患者的年龄、吸烟史、家族史等因素一起综合分析结节性质。
发现肺结节怎么办?
发现肺部结节不必惊慌,因为小结节是良性病变的概率更高。即使是癌,早发现,经过手术,很多患者是可以痊愈的。专科医生会根据结节的大小、影像特征、生长方式等综合判断其性质并给出诊治建议。
一般来说,6mm以下的结节,半年至一年复查CT随访即可。初次发现的8mm以上的磨玻璃结节,抗炎治疗或一至三个月随访后决定是否手术。6--8mm的磨玻璃结节可长期随访,也可以根据患者的焦虑程度、心肺功能等全身情况决定治疗方案。
手术切除肺结节创伤大吗?
目前肺结节的手术治疗主要采用微创技术,创伤小、并发症少、恢复快,良性肿瘤及大多数早期癌症术后一般不需要化疗和放疗。
查出肺结节,您不要紧张,听从专科医生的建议,科学理性地对待肺结节。